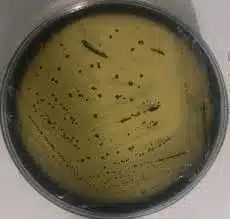

محیط کشت کلستریدیوم پرفرنجنس برای تشخیص و شناسایی این باکتری بیهوازی گرم مثبت طراحی شده است. این باکتری اسپورزا بوده و در محیطهای بیهوازی به خوبی رشد میکند. محیطهای کشت مختلفی برای کشت کلستریدیوم پرفرنجنس وجود دارد که هر کدام ویژگیهای خاص خود را دارند.
یکی از محیطهای کشت مورد استفاده، تیاِسبی (Tryptic Soy Broth) است که حاوی مواد مغذی لازم برای رشد باکتریها میباشد. این محیط معمولاً به همراه عوامل بیهوازیکننده به کار میرود تا شرایط بیهوازی فراهم شود.
شرکت دانش پژوهان شیمی وارد کننده اصلی مواد شیمیایی آزمایشگاهی بخصوص برند مرک آلمان و سیگماآلدریچ در ایران می باشد. جهت خرید محیط کشت می توانید با همکاران این مجموعه تماس حاصل نمائید.

کلستریدیوم پرفرنجنس، یکی از باکتریهای بیماریزای مهم است که در محیطهای مختلف یافت میشود. برای شناسایی و کشت این باکتری، از محیطهای کشت خاصی استفاده میشود که ویژگیهای خاصی دارند. در این مقاله به بررسی کامل محیط کشت کلستریدیوم پرفرنجنس میپردازیم و نکات کلیدی در مورد روشهای کشت و شناسایی این باکتری را توضیح میدهیم.
محیط کشت شاگئو (Schaedler Anaerobic Broth) یکی دیگر از محیطهای مناسب برای کشت کلستریدیوم پرفرنجنس است. این محیط حاوی مواد مغذی کامل و عوامل رشد دهنده برای باکتریهای بیهوازی میباشد و به طور خاص برای شناسایی این باکتری طراحی شده است.
محیط کشت خوندار (Blood Agar) نیز برای کشت کلستریدیوم پرفرنجنس استفاده میشود. این محیط شامل خون گوسفند بوده و میتواند همولیز ناشی از این باکتری را نشان دهد که یکی از ویژگیهای تشخیصی آن است.
کنترل دقیق شرایط بیهوازی و استفاده از محیطهای کشت مناسب از اهمیت بالایی برخوردار است تا نتایج دقیق و قابل اعتمادی به دست آید. خرید محیط کشت کلستریدیوم پرفرنجنس
کلستریدیوم پرفرنجنس یک باکتری گرم مثبت و بیهوازی است که میتواند عفونتهای جدی مانند گانگرن گازی و مسمومیتهای غذایی را ایجاد کند. این باکتری اسپورزا بوده و میتواند در شرایط سخت محیطی زنده بماند. تشخیص سریع و صحیح این باکتری اهمیت زیادی در پیشگیری و درمان عفونتهای ناشی از آن دارد.
گرم مثبت بودن
کلستریدیوم پرفرنجنس از دسته باکتریهای گرم مثبت است که در تست گرم رنگ بنفش میگیرد.
بیهوازی اجباری
این باکتری در شرایط بیهوازی (بدون اکسیژن) رشد میکند و در حضور اکسیژن نمیتواند زنده بماند.
تولید اسپور
کلستریدیوم پرفرنجنس اسپورزا بوده و میتواند در شرایط نامطلوب محیطی به شکل اسپور بقا پیدا کند.

محیط کشت تیاِسبی (Tryptic Soy Broth – TSB)
تیاِسبی یکی از محیطهای کشت مناسب برای رشد کلستریدیوم پرفرنجنس است. این محیط حاوی مواد مغذی مورد نیاز برای رشد باکتریها میباشد و میتواند در شرایط بیهوازی استفاده شود.
محیط کشت شاگئو (Schaedler Anaerobic Broth)
این محیط کشت مخصوص باکتریهای بیهوازی طراحی شده است و شامل مواد مغذی ضروری برای رشد کلستریدیوم پرفرنجنس میباشد. محیط کشت شاگئو یکی از بهترین محیطها برای شناسایی این باکتری به شمار میآید.
محیط کشت خوندار (Blood Agar)
محیط کشت خوندار برای شناسایی کلستریدیوم پرفرنجنس نیز مناسب است. این محیط حاوی خون گوسفند بوده و باکتریها را به خوبی تغذیه میکند. همچنین این محیط به تشخیص همولیز ناشی از کلستریدیوم پرفرنجنس کمک میکند.
شرکت دانش پژوهان شیمی که نمایندگی مرک آلمان و نمایندگی سیگماآلدریچ در ایران، با همکاری کارشناسان مجرب خود در بخش فنی و فروش، جهت تامین مواد اولیه پژوهش های تحقیقاتی ماده های با کیفیت بالا و قیمت مناسب را فراهم نموده است. شما می توانید جهت خرید محیط کشت کلستریدیوم پرفرنجنس با بخش فروش شرکت دانش پژوهان شیمی تماس حاصل بفرمایید و پس از دریافت پیش فاکتور و اطمینان حاصل نمودن از صحت نام محصول، کد، شماره CAS نامبر مواد شیمیایی درخواستی اقدام به ثبت سفارش نمایید تحویل کالاهای خریداری شده و زمان تحویل آنها به صورت زیر می باشد.
زمان ارسال سفارشات از انبار: ۲۴ تا ۴۸ ساعت کاری می باشد
نحوه ارسال کالای مشتریان: تهران توسط پیک
تست گرم
تست گرم اولین و مهمترین مرحله در شناسایی کلستریدیوم پرفرنجنس است. این باکتری در این تست به رنگ بنفش دیده میشود. خرید محیط کشت کلستریدیوم پرفرنجنس
کشت در شرایط بیهوازی
برای شناسایی دقیق کلستریدیوم پرفرنجنس، نمونهها باید در شرایط بیهوازی کشت داده شوند. این باکتری در حضور اکسیژن رشد نمیکند، بنابراین استفاده از جعبههای بیهوازی یا محیطهای کشت بیهوازی ضروری است.
تستهای بیوشیمیایی
تستهای بیوشیمیایی مانند تست کاتالاز و تستهای تخمیر قندها نیز برای شناسایی کلستریدیوم پرفرنجنس مورد استفاده قرار میگیرند.
تشخیص عفونتهای گانگرن گازی
یکی از مهمترین کاربردهای محیط کشت کلستریدیوم پرفرنجنس، تشخیص عفونتهای گانگرن گازی است. این عفونتها میتوانند تهدیدی جدی برای سلامت افراد باشند و تشخیص سریع آنها اهمیت زیادی دارد.
مسمومیتهای غذایی
کلستریدیوم پرفرنجنس یکی از عوامل اصلی مسمومیتهای غذایی است. استفاده از محیطهای کشت مناسب میتواند به شناسایی سریع این باکتری در نمونههای غذایی کمک کند.

تهیه و نگهداری محیط کشت
تهیه محیطهای کشت باید با دقت و طبق دستورالعملهای استاندارد انجام شود. همچنین نگهداری محیطهای کشت در دمای مناسب و شرایط استریل اهمیت زیادی دارد. خرید محیط کشت کلستریدیوم پرفرنجنس
کنترل شرایط بیهوازی
برای کشت موفق کلستریدیوم پرفرنجنس، کنترل دقیق شرایط بیهوازی ضروری است. استفاده از جعبههای بیهوازی و محیطهای کشت مخصوص بیهوازی به این امر کمک میکند. محیط کشت کلستریدیوم پرفرنجنس
انجام تستهای تأییدی
بعد از کشت و شناسایی اولیه، انجام تستهای تأییدی برای اطمینان از شناسایی صحیح باکتری ضروری است. این تستها شامل تستهای بیوشیمیایی و مولکولی میباشند. محیط کشت کلستریدیوم پرفرنجنس
کلستریدیوم بوتولینوم (Clostridium botulinum)
این باکتری تولید کننده سم بوتولینوم است که یکی از قویترین سموم شناخته شده میباشد. بوتولیسم، یک مسمومیت غذایی جدی، ناشی از مصرف غذاهای آلوده به این سم است. علائم بوتولیسم شامل ضعف عضلانی، فلج و در موارد شدید، مرگ است. محیط کشت کلستریدیوم پرفرنجنس
کلستریدیوم تتانی (Clostridium tetani)
کلستریدیوم تتانی عامل بیماری کزاز است. این باکتری از طریق زخمهای آلوده وارد بدن میشود و سمی به نام تتانوپاسمین تولید میکند که موجب اسپاسمهای عضلانی شدید میشود. واکسیناسیون علیه کزاز بهترین روش پیشگیری از این بیماری است.
کلستریدیوم دیفیسیل (Clostridium difficile)
این باکتری عامل اصلی عفونتهای رودهای مرتبط با مصرف آنتیبیوتیک است. علائم این عفونت شامل اسهال شدید و کولیت است. کلستریدیوم دیفیسیل میتواند باعث ایجاد بیماریهای رودهای شدید و تهدید کننده زندگی شود.
کلستریدیوم پرفرنجنس (Clostridium perfringens)
کلستریدیوم پرفرنجنس عامل گانگرن گازی و برخی مسمومیتهای غذایی است. این باکتری تولید کننده آنزیمها و توکسینهایی است که باعث تخریب بافتها و سلولها میشوند.
کلستریدیوم نووی (Clostridium novyi)
این باکتری میتواند عفونتهای بافت نرم و همچنین گانگرن گازی را ایجاد کند. کلستریدیوم نووی به طور خاص در بین حیوانات نیز بیماریزا است. خرید محیط کشت کلستریدیوم پرفرنجنس
کلستریدیوم سپتیکوم (Clostridium septicum)
این باکتری نیز میتواند باعث گانگرن گازی و عفونتهای شدید بافتی شود. عفونتهای ناشی از کلستریدیوم سپتیکوم اغلب به سرعت پیشرفت کرده و میتوانند کشنده باشند. محیط کشت کلستریدیوم پرفرنجنس
این گونهها نمونههایی از انواع کلستریدیوم هستند که به دلیل توانایی تولید سموم و اسپور، میتوانند باعث بیماریهای جدی شوند. شناسایی و تشخیص صحیح این باکتریها اهمیت زیادی در پیشگیری و درمان عفونتهای ناشی از آنها دارد.
کلستریدیوم پرفرنجنس یکی از باکتریهای مهم و بیماریزا است که نیاز به تشخیص سریع و دقیق دارد. استفاده از محیطهای کشت مناسب و روشهای شناسایی دقیق میتواند به تشخیص سریع و درمان به موقع عفونتهای ناشی از این باکتری کمک کند. با رعایت نکات گفته شده، میتوان از انتشار و عوارض ناشی از عفونتهای کلستریدیوم پرفرنجنس جلوگیری کرد.
مقدمه
باکتریهای کلستریدیوم جزو مهمترین و شناختهشدهترین باکتریهای بیماریزا هستند که نقش مهمی در بروز بسیاری از بیماریها دارند. این باکتریها به دلیل توانایی بالا در تولید سموم قوی و مقاومت در برابر شرایط محیطی سخت، توجه زیادی را به خود جلب کردهاند. در این مقاله به بررسی جامع این باکتریها، انواع آنها، مکانیزمهای بیماریزایی و راههای پیشگیری و درمان خواهیم پرداخت. محیط کشت کلستریدیوم پرفرنجنس
باکتریهای کلستریدیوم به چندین گونه مختلف تقسیم میشوند که هر کدام دارای ویژگیهای خاص خود هستند. برخی از مهمترین انواع این باکتری عبارتند از:
کلستریدیوم بوتولینوم
کلستریدیوم بوتولینوم مسئول تولید سم بوتولینوم است که یکی از قویترین سموم طبیعی جهان است. این سم میتواند باعث بوتولیسم شود، بیماریای که با فلج عضلات و در موارد شدید، مرگ همراه است. محیط کشت کلستریدیوم پرفرنجنس
کلستریدیوم تتانی
کلستریدیوم تتانی عامل بروز بیماری کزاز است. سم تولید شده توسط این باکتری، تتانوسپاسمین، باعث انقباضات شدید و دردناک عضلات میشود.
کلستریدیوم دیفیسیل
این باکتری عامل اصلی بروز اسهال و کولیت مرتبط با مصرف آنتیبیوتیکها است. سموم تولید شده توسط کلستریدیوم دیفیسیل باعث آسیب به دیواره روده و التهاب شدید میشود. محیط کشت کلستریدیوم پرفرنجنس
کلستریدیوم پرفرنژنس
کلستریدیوم پرفرنژنس عامل بروز گانگرن گازی است که میتواند به سرعت به بافتهای بدن آسیب برساند و در صورت عدم درمان به موقع، منجر به مرگ شود.
باکتریهای کلستریدیوم از طریق تولید سموم و آنزیمهای مختلف، نقش خود را در بیماریزایی ایفا میکنند. این مکانیزمها شامل موارد زیر میشوند:
تولید سموم
بسیاری از باکتریهای کلستریدیوم از طریق تولید سموم قوی مانند بوتولینوم، تتانوسپاسمین و توکسینهای کلستریدیوم دیفیسیل، باعث بروز بیماری میشوند. این سموم میتوانند به سیستم عصبی، عضلات و دستگاه گوارش آسیب برسانند.
ایجاد اسپور
کلستریدیومها توانایی تشکیل اسپور دارند که این امکان را به آنها میدهد تا در شرایط محیطی نامساعد بقا پیدا کنند. اسپورها میتوانند در محیط زنده باقی بمانند و زمانی که شرایط مناسب شد، به شکل فعال خود بازگردند و باعث بروز عفونت شوند. محیط کشت کلستریدیوم پرفرنجنس
برخی از کلستریدیومها آنزیمهایی را ترشح میکنند که به تجزیه بافتهای بدن میزبان کمک میکنند. این آنزیمها میتوانند بافتهای عضلانی و پیوندی را تخریب کرده و به گسترش عفونت کمک کنند.
راههای انتقال و عفونت
باکتریهای کلستریدیوم از طرق مختلفی میتوانند به انسانها منتقل شوند. برخی از این راهها عبارتند از:
مصرف مواد غذایی آلوده
بسیاری از عفونتهای ناشی از کلستریدیوم بوتولینوم و کلستریدیوم پرفرنژنس از طریق مصرف مواد غذایی آلوده به اسپورهای باکتری صورت میگیرد. این مواد غذایی ممکن است شامل کنسروها، گوشتها و سبزیجاتی باشند که به درستی نگهداری نشدهاند.
آلودگی زخمها
کلستریدیوم تتانی و کلستریدیوم پرفرنژنس میتوانند از طریق زخمهای باز و آلوده وارد بدن شوند. این باکتریها در زخمهای عمیق و کم اکسیژن به سرعت تکثیر میشوند و سموم خود را ترشح میکنند.
مصرف نادرست و بیش از حد آنتیبیوتیکها میتواند باعث کاهش جمعیت باکتریهای مفید روده و افزایش رشد کلستریدیوم دیفیسیل شود. این باکتریها با تولید سموم خود باعث بروز اسهال و کولیت میشوند.
روشهای پیشگیری و درمان
پیشگیری و درمان عفونتهای ناشی از کلستریدیومها به شناسایی و کنترل عوامل خطر و استفاده از روشهای درمانی مناسب بستگی دارد. برخی از این روشها شامل موارد زیر هستند:
حفظ بهداشت مواد غذایی
یکی از مهمترین راههای پیشگیری از عفونتهای کلستریدیومی، رعایت بهداشت مواد غذایی است. این شامل پخت و پز مناسب، نگهداری صحیح مواد غذایی و جلوگیری از مصرف مواد غذایی آلوده میشود.
واکسیناسیون علیه بیماریهایی مانند کزاز میتواند به پیشگیری از عفونتهای ناشی از کلستریدیوم تتانی کمک کند. این واکسنها به خصوص برای افراد در معرض خطر مانند کارکنان بهداشتی و نظامیان توصیه میشود.
استفاده صحیح از آنتیبیوتیکها و اجتناب از مصرف بیرویه آنها میتواند به کاهش خطر عفونتهای ناشی از کلستریدیوم دیفیسیل کمک کند. پزشکان باید با دقت و بر اساس نیاز بیمار، آنتیبیوتیکها را تجویز کنند.
درمان عفونتهای کلستریدیومی معمولاً شامل استفاده از آنتیبیوتیکهای مناسب است. برای مثال، درمان بوتولیسم با آنتیتوکسینها و درمان گانگرن گازی با آنتیبیوتیکها و جراحی انجام میشود. در موارد شدید، ممکن است نیاز به بستری در بیمارستان و مراقبتهای ویژه باشد.
باکتریهای کلستریدیوم به دلیل توانایی بالا در تولید سموم قوی و مقاومت در برابر شرایط محیطی سخت، از جمله مهمترین باکتریهای بیماریزا محسوب میشوند. آشنایی با انواع این باکتریها، مکانیزمهای بیماریزایی و راههای پیشگیری و درمان میتواند به کاهش خطر عفونتها و بهبود سلامت عمومی کمک کند. محیط کشت کلستریدیوم پرفرنجنس
شرکت دانش پژوهان شیمیی یکی از بزرگترین وارد کنندگان و فروشندگان مواد شیمیایی و آزمایشگاهی بخصوص فروش محیط کشت کلستریدیوم پرفرنجنس می باشد. این شرکت در زمینه واردات این محصولات از تجربه بسیار بالایی برخوردار است. شما می توانید جهت تهیه این محصولات (اصلی) با بخش فروش شرکت تماس گرفته و با کارشناسان این شرکت در ارتباط باشید و یا از طریق کانال واتساپ شرکت نام محصول به همراه میزان نیاز خود را ارسال تا در کمترین زمان پاسخ استعلام خود را دریافت نمائید.امیدواریم بتوانیم با ارائه محصولات اصلی و با بهترین کیفیت شما را برای رسیدن به اهدافتان یاری نمائیم.
جهت محصولات بیشتر واستعلام سریع قیمت محیط کشت کلستریدیوم پرفرنجنس میتوانید از طریق کانال واتساپ شرکت با ارسال نام ماده و مقدار نیاز در کمترین زمان پاسخ استعلام خود را دریافت نمائید.
راههای ارتباطی
شماره های تماس:
021-66859216
021-66859220 (ساعات تماس:8.30 الی 19)
واتساپ:09129618292 (24ساعت)
Last Updated on 08/01/2024 by adminm